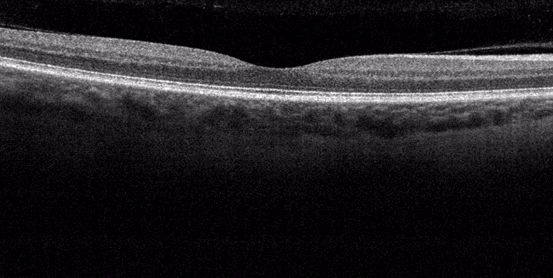

Vyšetřovací postupy
Pracoviště: Oční klinika dětí a dospělých 2. LF UK a FN Motol
Vloženo: 13. 9. 2017
Anamnéza
Oční lékař se zajímá o typ a dobu trvání diabetu, stav kompenzace diabetu vyjádřený hodnotou glykovaného hemoglobinu HbA1C, přítomnost specifických mikrovaskulárních komplikací diabetu (diabetická nefropatie, diabetické neuropatie), přítomnost srdečních a cévních onemocnění. Zajímá se rovněž o poruchy tukového (lipidového) metabolismu, hodnotu krevního tlaku, historii kouření a další onemocnění, která mohou zvyšovat riziko rozvoje očních komplikací.
Z oční anamnézy je důležitý výskyt očních onemocnění v rodině, dále chronická oční léčba, oční operace, laserové zákroky, úrazy oka, používání brýlí. Důležitá je kvalita vidění na dálku a blízko, kolísání vidění, přítomnost poruch vidění, obtíže při čtení, které neustoupí při použití brýlí na čtení, zvláště deformace linií či písmen, nebo jejich vypadávání.
Vyšetření zrakové ostrosti
Zraková ostrost je zodpovědná za naši schopnost rozeznat detaily, které sledujeme. Určuje se zraková ostrost na dálku, většinou z 5 či 6 metrů. Zraková ostrost na blízko odpovídá čtecí vzdálenosti, obvykle 30 cm. Vyšetření zrakové ostrosti určuje míru centrální ostrosti. Hodnota zrakové ostrosti je označována jako tzv. vízus, používá se celá řada zápisů.
Nejčastěji používané zápisy 5/5 nebo 6/6 či 1,0 znamenají plnou zrakovou ostrost.
.jpg) Optotyp – jeden z mnoha možných přístrojů k vyšetření zrakové ostrosti
Optotyp – jeden z mnoha možných přístrojů k vyšetření zrakové ostrosti
Amslerova mřížka
Slouží k subjektivnímu vyšetření žluté skvrny. Pokud je přítomný otok místa nejostřejšího vidění, dochází k prohnutí či deformaci čar tvořících mřížku.
 Obr. Amslerova mřížka
Obr. Amslerova mřížka
Jak používat Amslerovu mřížku
- Používejte mřížku pravidelně, alespoň jednou týdně.
- Pokud používáte brýle na čtení, nasaďte si je.
- Zakryjte si jedno oko (například rukou nebo složeným kapesníkem).
- Pozorujte mřížku ze vzdálenosti přibližně 30 – 40 cm v dobře osvětlené místnosti.
- Dívejte se pouze na černý bod uprostřed obrázku, nepohybujte okem po celé čtvercové síti.
- Sledujte, zda vidíte čtvercovou síť jako pravidelnou, zda některé čtverce nechybí nebo nejsou deformovány.
- Proveďte zkoušku pro každé oko zvlášť.
Zaznamenáte-li nepravidelnosti v průběhu čar, například deformace či přerušení čar, neprodleně informujte svého očního lékaře.
 Obr. Amslerova mřížka: Příklad jak může mřížku vidět pacient s diabetickým makulárním edémem
Obr. Amslerova mřížka: Příklad jak může mřížku vidět pacient s diabetickým makulárním edémem
Vyšetření štěrbinovou lampou - mikroskopem
Lékař zhodnotí stav předního segmentu oka. Pro vyšetření očního pozadí - sítnice, je nutné rozšíření zorniček (mydriáza) pomocí aplikace speciálních očních kapek, tzv. rozkapání. Efekt mydriatických kapek nastupuje cca po 30 minutách a přetrvává dle použitého typu kapek 3 až 24 hodin. Při dostatečném rozšíření zorniček je následně vyšetřena sítnice.
Do odeznění efektu rozkapání není možné řídit motorová vozidla. Při slunečných dnech je vhodné oči chránit slunečními brýlemi.
Poznámka redakce:
V současné době jsou také k dispozici běžné sítnicové kamery s výkonným počítačem využívajícím schopnosti umělé inteligence. Na jednu z nich upozorňuje aktualita "Diabetická retinopatie – jedna z nejčastějších komplikací diabetu."
Fotodokumentace
Fotodokumentace je zvláště důležitá pro zachycení změn sítnice v čase během dalších kontrol, pro správné načasování léčby nebo zhodnocení efektu léčby.
 Obr. Foto normální sítnice - žlutá skvrna, zrakový terč, cévy sítnice
Obr. Foto normální sítnice - žlutá skvrna, zrakový terč, cévy sítnice
Optická koherenční tomografie - OCT
Jedná se o neinvazivní vyšetření, které nezatěžuje pacienta. Pracuje na podobném principu jako ultrazvuk. Místo zvukové vlny je použit světelný paprsek. Umožňuje opakovaně vyšetřit sítnici na úrovni histologického řezu. Na snímcích jsou patrny jednotlivé vrstvy sítnice. OCT je důležitá ke zjištění diabetického makulárního edému a celé řady dalších onemocnění žluté skvrny (makuly).
Obr. OCT obraz normální sítnice
Obr. OCT obraz normální sítnice
 Obr. OCT ve 3D zobrazení: normální obraz centra vidění (žlutá skvrna)
Obr. OCT ve 3D zobrazení: normální obraz centra vidění (žlutá skvrna)
 Obr. OCT ve 3D zobrazení: řez centrem vidění (žlutá skvrna)
Obr. OCT ve 3D zobrazení: řez centrem vidění (žlutá skvrna)
Fluorescenční angiografie
Po nitrožilní aplikaci barviva obsahujícího fluorescein do krevního řečiště se zobrazí jemná cévní kresba sítnice. Zviditelní se oblasti se sníženým prokrvením, novotvořené cévy a zdroje prosakování tekutiny při diabetickém makulárním edému. Možným rizikem při fluorescenční angiografii je alergická reakce na podávané barvivo.

 Obr. Fluorescenční angiografie
Obr. Fluorescenční angiografie


